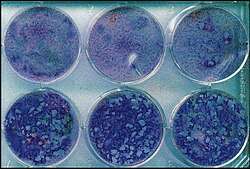

Aciclovir
![]() | |
![]() | |
| Clinical data | |
|---|---|
| Pronunciation | /eɪˈsaɪkloʊvɪər/ |
| Trade names | Zovirax, others[1] |
| Other names | Acycloguanosine, acyclovir (BAN UK), acyclovir (USAN US) |
| AHFS/Drugs.com | |
| MedlinePlus | a681045 |
| License data |
|
| Pregnancy category |
|
| Routes of administration | Intravenous, by mouth, topical, eye ointment |
| ATC code | |
| Legal status | |
| Legal status |
|
| Pharmacokinetic data | |
| Bioavailability | 15–20% (by mouth)[3] |
| Protein binding | 9–33%[3] |
| Metabolism | Liver |
| Elimination half-life | 2–4 hours |
| Excretion | Kidney (62–90% as unchanged drug) |
| Identifiers | |
IUPAC name
| |
| CAS Number | |
| PubChem CID | |
| PubChem SID | |
| IUPHAR/BPS | |
| DrugBank | |
| ChemSpider | |
| UNII | |
| KEGG | |
| ChEBI | |
| ChEMBL | |
| PDB ligand | |
| CompTox Dashboard (EPA) | |
| ECHA InfoCard | 100.056.059 |
| Chemical and physical data | |
| Formula | C8H11N5O3 |
| Molar mass | 225.208 g·mol−1 |
| 3D model (JSmol) | |
| Melting point | 256.5 °C (493.7 °F) |
SMILES
| |
InChI
| |
| (verify) | |
Aciclovir, also known as acyclovir,[4] is an antiviral medication.[5] It is primarily used for the treatment of herpes simplex virus infections, chickenpox, and shingles.[6] Other uses include the prevention of cytomegalovirus infections following transplant, and severe complications of Epstein–Barr virus infection.[6][7] It can be taken by mouth, applied as a cream, or injected.[6]
Common side effects include nausea and diarrhea.[6] Potentially serious side effects include kidney problems and low platelets.[6] Greater care is recommended in those with poor liver or kidney function.[6] It is generally considered safe for use in pregnancy with no harm having been observed.[6][8] It appears to be safe during breastfeeding.[9][10] Aciclovir is a nucleoside analogue that mimics guanosine.[6] It works by decreasing the production of the virus's DNA.[6]
Aciclovir was patented in 1974, by Burroughs Wellcome, and approved for medical use in 1981.[11] It is on the World Health Organization's List of Essential Medicines.[12] It is available as a generic medication and is marketed under many brand names worldwide.[1] In 2023, it was the 150th most commonly prescribed medication in the United States, with more than 3 million prescriptions.[13][14]
Medical use

Aciclovir acts by inhibiting viral DNA replication and is used for the treatment of herpes simplex virus (HSV) and varicella zoster virus infections, including:[3][15][16]
- Genital herpes simplex (treatment and prevention)
- Neonatal herpes simplex
- Herpes simplex labialis (cold sores)
- Shingles
- Acute chickenpox in immunocompromised patients
- Herpes simplex encephalitis
- Acute mucocutaneous HSV infections in immunocompromised patients
- Herpes of the eye and herpes simplex blepharitis (a chronic (long-term) form of herpes eye infection)
- Prevention of herpes viruses in immunocompromised people (such as people undergoing cancer chemotherapy)[17]
It has not been found to be effective against Epstein–Barr virus and its associated infectious mononucleosis.[18] Aciclovir risks causing resistance to antiviral agents, and in 1% to 10% of cases can cause unpleasant side effects.[19]
Aciclovir taken by mouth does not appear to decrease the risk of pain after shingles.[20] In those with herpes of the eye, aciclovir may be more effective and safer than idoxuridine.[21] It is unclear if aciclovir eye drops are more effective than brivudine eye drops.[21]
Intravenous aciclovir is effective in treating severe medical conditions caused by different species of the herpes virus family, including severe localized infections of the herpes virus, severe genital herpes, chickenpox and herpesviral encephalitis. It is also effective in systemic or traumatic herpes infections, eczema herpeticum, and herpesviral meningitis. Reviews of research dating from the 1980s show there is some effect in reducing the number and duration of lesions if aciclovir is applied at an early stage of an outbreak.[22] Research shows effectiveness of topical aciclovir in both the early and late stages of the outbreak as well as improving methodologically and in terms of statistical certainty from previous studies.[23] Aciclovir trials show that this agent has no role in preventing HIV transmission, but it can help slow HIV disease progression in people not taking anti-retroviral therapy (ART). This finding emphasizes the importance of testing simple, inexpensive non-ART strategies, such as aciclovir and cotrimoxazole, in people with HIV.[24]
Pregnancy
The CDC and others have declared that during severe recurrent or first episodes of genital herpes, aciclovir may be used.[25] For severe HSV infections (especially disseminated HSV), IV aciclovir may also be used.[26]
Studies in mice, rabbits, and rats (with doses more than 10 times the equivalent of that used in humans) given during organogenesis have failed to demonstrate birth defects.[27] Studies in rats in which they were given the equivalent to 63 times the standard steady-state human concentrations of the drug[Note 1] on day 10 of gestation showed head and tail anomalies.[27]
Aciclovir is recommended by the CDC for treatment of varicella during pregnancy, especially during the second and third trimesters.[28]
Aciclovir is excreted in breast milk, therefore it is recommended that caution should be used in breast-feeding women. It has been shown in limited test studies that the nursing infant is exposed to approximately 0.3 mg/kg/day following oral administration of aciclovir to the mother. If nursing mothers have herpetic lesions near or on the breast, breast-feeding should be avoided.[29][30]
Adverse effects
Systemic therapy
Common adverse drug reactions (≥1% of patients) associated with systemic aciclovir therapy (oral or IV) include nausea, vomiting, diarrhea, encephalopathy (with IV use only), injection site reactions (with IV use only) and headache. In high doses, hallucinations have been reported. Infrequent adverse effects (0.1–1% of patients) include agitation, vertigo, confusion, dizziness, oedema, arthralgia, sore throat, constipation, abdominal pain, hair loss, rash and weakness. Rare adverse effects (<0.1% of patients) include coma, seizures, neutropenia, leukopenia, crystalluria, anorexia, fatigue, hepatitis, Stevens–Johnson syndrome, toxic epidermal necrolysis, thrombotic thrombocytopenic purpura, anaphylaxis,[15] and Cotard's syndrome.
Intravenous aciclovir may cause reversible nephrotoxicity in up to 5% to 10% of patients because of precipitation of aciclovir crystals in the kidney. Aciclovir crystalline nephropathy is more common when aciclovir is given as a rapid infusion and in patients with dehydration and preexisting renal impairment. Adequate hydration, a slower rate of infusion, and dosing based on renal function may reduce this risk.[31][32][33]
The aciclovir metabolite 9-Carboxymethoxymethylguanine (9-CMMG) has been shown to play a role in neurological adverse events, particularly in older people and those with reduced renal function.[34][35][36]
Topical therapy
Aciclovir topical cream is commonly associated (≥1% of patients) with dry or flaking skin or transient stinging/burning sensations. Infrequent adverse effects include erythema or itch.[15] When applied to the eye, aciclovir is commonly associated (≥1% of patients) with transient mild stinging. Infrequently (0.1–1% of patients), ophthalmic aciclovir is associated with superficial punctate keratitis or allergic reactions.[15]
Drug interactions
Ketoconazole: In-vitro replication studies have found a synergistic, dose-dependent antiviral activity against HSV-1 and HSV-2 when given with aciclovir. However, this effect has not been clinically established and more studies need to be done to evaluate the true potential of this synergy.[37]
Probenecid: Reports of increased half-life of aciclovir, as well as decreased urinary excretion and renal clearance have been shown in studies where probenecid is given simultaneously with aciclovir.[29]
Interferon: Synergistic effects when administered with aciclovir and caution should be taken when administering aciclovir to patients receiving IV interferon.[38]
Zidovudine: Although administered often with aciclovir in HIV patients, neurotoxicity has been reported in at least one patient who presented with extreme drowsiness and lethargy 30–60 days after receiving IV aciclovir; symptoms resolved when aciclovir was discontinued.[39]
Detection in biological fluids
Aciclovir may be quantitated in plasma or serum to monitor for drug accumulation in patients with renal dysfunction or to confirm a diagnosis of poisoning in acute overdose victims.[40]
Mechanism of action


Aciclovir is converted by viral thymidine kinase to aciclovir monophosphate, which is then converted by host cell kinases to aciclovir triphosphate (ACV-TP, also known as aciclo-GTP).[27] ACV-TP is a very potent inhibitor of viral DNA replication. ACV-TP competitively inhibits and inactivates the viral DNA polymerase.[41] Its monophosphate form also incorporates into the viral DNA, resulting in chain termination.[27][42][43]
Resistance
Resistance to aciclovir is rare in people with healthy immune systems but is more common (up to 10%) in people with immunodeficiencies on chronic antiviral prophylaxis (transplant recipients, people with acquired immunodeficiency syndrome due to HIV infection). Mechanisms of resistance in HSV include deficient viral thymidine kinase; and mutations to viral thymidine kinase or DNA polymerase, altering substrate sensitivity.[44][45]
Microbiology
Aciclovir is active against most species in the herpesvirus family. In descending order of activity:[46][47]
- Herpes simplex virus type I (HSV-1)
- Herpes simplex virus type II (HSV-2)
- Varicella zoster virus
- Epstein–Barr virus
- Human cytomegalovirus – least activity
Pharmacokinetics
Aciclovir is poorly water-soluble and has poor oral bioavailability (15–30%), hence intravenous administration is necessary if high concentrations are required. When orally administered, peak plasma concentration occurs after 1–2 hours. According to the Biopharmaceutical Classification System, aciclovir is a Class III drug, i.e., soluble with low intestinal permeability.[48] Aciclovir has a high distribution rate; protein binding is reported to range from 9 to 33%.[49] The elimination half-life (t1/2) of aciclovir depends according to age group; neonates have a t1/2 of 4 hours, children 1–12 years have a t1/2 of 2–3 hours whereas adults have a t1/2 of 3 hours.[3]
Chemistry
Details of the synthesis of aciclovir were first published by scientists from the University at Buffalo.[50]
In the first step shown, 2,6-dichloropurine was alkylated with 1-benzoyloxy-2-chloromethoxyethane. The chlorine group at the 6-position of the heterocyclic ring is more reactive than the chlorine at the 2-position, hence it can be selectively replaced by an amino group, which was then converted to an amide using nitrous acid. Finally, the remaining chlorine was replaced by the amino group of aciclovir using ammonia in methanol.[51] This synthesis and other methods for preparing the compound have been reviewed.[52]
History
.jpg)
Aciclovir was seen as the start of a new era in antiviral therapy, as it is extremely selective and low in cytotoxicity.[5] Since the discovery in the mid-1970s, it has been used as an effective drug for the treatment of infections caused by most known species of the herpesvirus family, including herpes simplex and varicella zoster viruses. Nucleosides isolated from a Caribbean sponge, Cryptotethya crypta, were the basis for the synthesis of aciclovir.[53][54][55] It was codiscovered by Howard Schaeffer following his work with Robert Vince, S. Bittner and S. Gurwara on the adenosine analog acycloadenosine which showed promising antiviral activity.[50] Later, Schaeffer joined Burroughs Wellcome and continued the development of aciclovir with pharmacologist Gertrude B. Elion.[56] A U.S. patent on aciclovir listing Schaeffer as inventor was issued in 1979.[57] Vince later invented abacavir, an nRTI drug for HIV patients.[58] Elion was awarded the 1988 Nobel Prize in Medicine, partly for the development of aciclovir.[59]
A related prodrug form, valaciclovir came into medical use in 1995. It is converted to aciclovir in the body after absorption.[60]
In 2009, acyclovir in combination with hydrocortisone cream, marketed as Xerese, was approved in the United States for the early treatment of recurrent herpes labialis (cold sores) to reduce the likelihood of ulcerative cold sores and to shorten the lesion healing time in adults and children (six years of age and older).[61][62]
Veterinary use
Aciclovir is not commonly used in veterinary medicine: there is no evidence of its efficacy for most herpesviruses. In horses the oral bioavailability is just 3% and intravenous use is required to treat equine herpes virus 1. In cats the drug is poorly absorbed and produces toxicity and feline herpes virus 1 is resistant to it.[63]
Society and culture
Names
It was originally marketed as Zovirax; patents expired in the 1990s and since then it has been generic and is marketed under many brand names worldwide.[1]
Notes
- ^ Subject to the same conditions as before
References
- ^ a b c "Aciclovir". Drugs.com. Archived from the original on 23 September 2015. Retrieved 6 September 2015.
- ^ "Skin health". Health Canada. 9 May 2018. Retrieved 13 April 2024.
- ^ a b c d "Zovirax (acyclovir) dosing, indications, interactions, adverse effects, and more". Medscape Reference. WebMD. Archived from the original on 19 February 2014. Retrieved 5 February 2014.
- ^ Kevin ES. "The Aciclovir" (in German). Kevin. Retrieved 25 May 2017.
- ^ a b de Clercq E, Field HJ (5 October 2005). "Antiviral prodrugs – the development of successful prodrug strategies for antiviral chemotherapy". British Journal of Pharmacology. Vol. 147, no. 1. Wiley-Blackwell (published January 2006). pp. 1–11. doi:10.1038/sj.bjp.0706446. PMC 1615839. PMID 16284630.
- ^ a b c d e f g h i "Acyclovir". The American Society of Health-System Pharmacists. Archived from the original on 2015-01-05. Retrieved Jan 1, 2015.
- ^ Rafailidis PI, Mavros MN, Kapaskelis A, Falagas ME (November 2010). "Antiviral treatment for severe EBV infections in apparently immunocompetent patients". Journal of Clinical Virology. 49 (3): 151–157. doi:10.1016/j.jcv.2010.07.008. PMID 20739216.
- ^ "Prescribing medicines in pregnancy database". Australian Government. 3 March 2014. Archived from the original on 8 April 2014. Retrieved 22 April 2014.
- ^ Hamilton R (2015). Tarascon Pocket Pharmacopoeia 2015 Deluxe Lab-Coat Edition. Jones & Bartlett Learning. p. 59. ISBN 978-1-284-05756-0.
- ^ "Acyclovir use while Breastfeeding". Mar 10, 2015. Archived from the original on 5 March 2016. Retrieved 8 March 2016.
Even with the highest maternal dosages, the dosage of acyclovir in milk is only about 1% of a typical infant dosage and would not be expected to cause any adverse effects in breastfed infants
- ^ Fischer J, Ganellin CR (2006). Analogue-based Drug Discovery. John Wiley & Sons. p. 504. ISBN 978-3-527-60749-5.
- ^ The selection and use of essential medicines 2023: web annex A: World Health Organization model list of essential medicines: 23rd list (2023). Geneva: World Health Organization. 2023. hdl:10665/371090. WHO/MHP/HPS/EML/2023.02.
- ^ "Top 300 of 2023". ClinCalc. Archived from the original on 12 August 2025. Retrieved 12 August 2025.
- ^ "Acyclovir Drug Usage Statistics, United States, 2013 - 2023". ClinCalc. Retrieved 18 August 2025.
- ^ a b c d Rossi, S, ed. (2013). Australian Medicines Handbook (2013 ed.). Adelaide: The Australian Medicines Handbook Unit Trust. ISBN 978-0-9805790-9-3.
- ^ Joint Formulary Committee (2013). British National Formulary (BNF) (65 ed.). London: Pharmaceutical Press. ISBN 978-0-85711-084-8.
- ^ Elad S, Zadik Y, Hewson I, Hovan A, Correa ME, Logan R, et al. (August 2010). "A systematic review of viral infections associated with oral involvement in cancer patients: a spotlight on Herpesviridea". Supportive Care in Cancer. 18 (8): 993–1006. doi:10.1007/s00520-010-0900-3. PMID 20544224. S2CID 2969472.
- ^ Gershburg E, Pagano JS (August 2005). "Epstein-Barr virus infections: prospects for treatment". The Journal of Antimicrobial Chemotherapy. 56 (2): 277–281. CiteSeerX 10.1.1.320.6721. doi:10.1093/jac/dki240. PMID 16006448.
- ^ De Paor M, O'Brien K, Fahey T, Smith SM (December 2016). "Antiviral agents for infectious mononucleosis (glandular fever)". The Cochrane Database of Systematic Reviews. 2016 (12) CD011487. doi:10.1002/14651858.CD011487.pub2. PMC 6463965. PMID 27933614.
- ^ Chen N, Li Q, Yang J, Zhou M, Zhou D, He L (February 2014). "Antiviral treatment for preventing postherpetic neuralgia". The Cochrane Database of Systematic Reviews. 2014 (2) CD006866. doi:10.1002/14651858.CD006866.pub3. PMC 10583132. PMID 24500927.
- ^ a b Wilhelmus KR (January 2015). "Antiviral treatment and other therapeutic interventions for herpes simplex virus epithelial keratitis". The Cochrane Database of Systematic Reviews. 1 (1) CD002898. doi:10.1002/14651858.CD002898.pub5. PMC 4443501. PMID 25879115.
- ^ Worrall G (January 1996). "Acyclovir in recurrent herpes labialis". BMJ. 312 (7022): 6. doi:10.1136/bmj.312.7022.6. PMC 2349724. PMID 8555890. Archived from the original on 2007-05-15. – Editorial
- ^ Spruance SL, Nett R, Marbury T, Wolff R, Johnson J, Spaulding T (July 2002). "Acyclovir cream for treatment of herpes simplex labialis: results of two randomized, double-blind, vehicle-controlled, multicenter clinical trials". Antimicrobial Agents and Chemotherapy. 46 (7): 2238–2243. doi:10.1128/aac.46.7.2238-2243.2002. PMC 127288. PMID 12069980.
- ^ Mascolinli M, Kort R (June 2010). "5th International AIDS Society Conference on HIV Pathogenesis, Treatment and Prevention: summary of key research and implications for policy and practice - biomedical prevention". Journal of the International AIDS Society. 13 (Suppl 1): S4. doi:10.1186/1758-2652-13-S1-S4. PMC 2880255. PMID 20519025.
- ^ "Drugs for non-HIV viral infections". Treatment Guidelines from the Medical Letter. 3 (32): 23–32. April 2005. PMID 15767977.
- ^ Kaplan JE, Benson C, Holmes KK, Brooks JT, Pau A, Masur H (April 2009). "Guidelines for prevention and treatment of opportunistic infections in HIV-infected adults and adolescents: recommendations from CDC, the National Institutes of Health, and the HIV Medicine Association of the Infectious Diseases Society of America". MMWR. Recommendations and Reports. 58 (RR-4): 1–207, quiz CE1–4. PMID 19357635.
- ^ a b c d "PRODUCT INFORMATION NAME OF THE DRUG OZVIR TABLETS" (PDF). TGA eBusiness Services. Ranbaxy Australia Pty Ltd. 26 August 2011. Archived from the original on 20 August 2016. Retrieved 6 February 2014.
- ^ Centers for Disease Control and Prevention. (January 2006). Epidemiology and prevention of vaccine-preventable diseases (9th ed.). Public Health Foundation. pp. 171–192.
- ^ a b "Acyclovir label" (PDF). GSK. FDA. 2005. Archived (PDF) from the original on 2017-09-08.
- ^ Gartner LM, Morton J, Lawrence RA, Naylor AJ, O'Hare D, Schanler RJ, et al. (February 2005). "Breastfeeding and the use of human milk". Pediatrics. 115 (2): 496–506. doi:10.1542/peds.2004-2491. PMID 15687461. S2CID 5791615.
- ^ Razonable RR (October 2011). "Antiviral drugs for viruses other than human immunodeficiency virus". Mayo Clinic Proceedings. 86 (10): 1009–1026. doi:10.4065/mcp.2011.0309. PMC 3184032. PMID 21964179.
- ^ Brigden D, Rosling AE, Woods NC (July 1982). "Renal function after acyclovir intravenous injection". The American Journal of Medicine. 73 (1A): 182–185. doi:10.1016/0002-9343(82)90087-0. PMID 6285711.
- ^ Sawyer MH, Webb DE, Balow JE, Straus SE (June 1988). "Acyclovir-induced renal failure. Clinical course and histology". The American Journal of Medicine. 84 (6): 1067–1071. doi:10.1016/0002-9343(88)90313-0. PMID 3376977.
- ^ Helldén A, Odar-Cederlöf I, Diener P, Barkholt L, Medin C, Svensson JO, et al. (June 2003). "High serum concentrations of the acyclovir main metabolite 9-carboxymethoxymethylguanine in renal failure patients with acyclovir-related neuropsychiatric side effects: an observational study". Nephrology, Dialysis, Transplantation. 18 (6): 1135–1141. doi:10.1093/ndt/gfg119. PMID 12748346.
- ^ Berry L, Venkatesan P (December 2014). "Aciclovir-induced neurotoxicity: Utility of CSF and serum CMMG levels in diagnosis". Journal of Clinical Virology. 61 (4): 608–610. doi:10.1016/j.jcv.2014.09.001. PMID 25440915.
- ^ Chowdhury MA, Derar N, Hasan S, Hinch B, Ratnam S, Assaly R (2016). "Acyclovir-Induced Neurotoxicity: A Case Report and Review of Literature". American Journal of Therapeutics. 23 (3): e941–e943. doi:10.1097/MJT.0000000000000093. PMID 24942005. S2CID 32983100.
- ^ Pottage JC, Kessler HA, Goodrich JM, Chase R, Benson CA, Kapell K, et al. (August 1986). "In vitro activity of ketoconazole against herpes simplex virus". Antimicrobial Agents and Chemotherapy. 30 (2): 215–219. doi:10.1128/aac.30.2.215. PMC 180521. PMID 3021048.
- ^ GlaxoSmithKline. Zovirax® (acyclovir sodium) for injection prescribing information. Research Triangle Park, NC; 2003 Nov
- ^ Bach MC (February 1987). "Possible drug interaction during therapy with azidothymidine and acyclovir for AIDS". The New England Journal of Medicine. 316 (9): 547. doi:10.1056/NEJM198702263160912. PMID 3468354.
- ^ Baselt RC (2008). Disposition of toxic drugs and chemicals in man (8th ed.). Foster City, CA: Biomedical Publications. pp. 29–31. ISBN 978-0-9626523-7-0.
- ^ "VALTREX (valacyclovir hydrochloride) Caplets -GSKSource". gsksource.com. Retrieved 2019-08-02.
- ^ "Acyclovir (acyclovir) Capsule Acyclovir (acyclovir) Tablet [Genpharm Inc.]". DailyMed. Genpharm Inc. November 2006. Archived from the original on 21 February 2014. Retrieved 5 February 2014.
- ^ "Aciclovir Tablets BP 400mg - Summary of Product Characteristics (SPC)". electronic Medicines Compendium. Actavis UK Ltd. 20 August 2012. Archived from the original on 22 February 2014. Retrieved 5 February 2014.
- ^ Sweetman, S, ed. (7 August 2013). "Aciclovir". Martindale: The Complete Drug Reference. London, UK: Pharmaceutical Press. Retrieved 6 February 2014.
- ^ Piret J, Boivin G (February 2011). "Resistance of herpes simplex viruses to nucleoside analogues: mechanisms, prevalence, and management". Antimicrobial Agents and Chemotherapy. 55 (2): 459–472. doi:10.1128/AAC.00615-10. PMC 3028810. PMID 21078929.
- ^ O'Brien JJ, Campoli-Richards DM (March 1989). "Acyclovir. An updated review of its antiviral activity, pharmacokinetic properties and therapeutic efficacy". Drugs. 37 (3): 233–309. doi:10.2165/00003495-198937030-00002. PMID 2653790. S2CID 240858022.
- ^ Wagstaff AJ, Faulds D, Goa KL (January 1994). "Aciclovir. A reappraisal of its antiviral activity, pharmacokinetic properties and therapeutic efficacy". Drugs. 47 (1): 153–205. doi:10.2165/00003495-199447010-00009. PMID 7510619.
- ^ Karmoker JR, Hasan I, Ahmed N, Saifuddin M, Reza MS (2019). "Development and Optimization of Acyclovir Loaded Mucoadhesive Microspheres by Box -Behnken Design". Dhaka University Journal of Pharmaceutical Sciences. 18 (1): 1–12. doi:10.3329/dujps.v18i1.41421.
- ^ "Aciclovir Tablets BP 400mg - Summary of Product Characteristics (SmPC) - (emc)". www.medicines.org.uk.
- ^ a b Schaeffer HJ, Gurwara S, Vince R, Bittner S (April 1971). "Novel substrate of adenosine deaminase". Journal of Medicinal Chemistry. 14 (4): 367–369. doi:10.1021/jm00286a024. PMID 5553754.
- ^ US patent 4199574, Schaeffer HJ, "Methods and compositions for treating viral infections and guanine acyclic nucleosides", published 1980-04-22, assigned to Burroughs Wellcome.
- ^ Vardanyan R, Hruby V (2016). "34: Antiviral Drugs". Synthesis of Best-Seller Drugs. Academic Press. pp. 706–708. doi:10.1016/B978-0-12-411492-0.00034-1. ISBN 978-0-12-411492-0. S2CID 75449475.
- ^ Garrison T (1999). Oceanography: An Invitation to Marine Science, 3rd ed. Belmont, CA: Wadsworth Publishing Company. p. 471.
- ^ Sepčić K (2000). "Bioactive Alkylpyridinium Compounds from Marine Sponges". Toxin Reviews. 19 (2): 139–160. doi:10.1081/TXR-100100318. S2CID 84041855.
- ^ Laport MS, Santos OC, Muricy G (January 2009). "Marine sponges: potential sources of new antimicrobial drugs". Current Pharmaceutical Biotechnology. 10 (1): 86–105. doi:10.2174/138920109787048625. PMID 19149592.
- ^ Elion GB, Furman PA, Fyfe JA, de Miranda P, Beauchamp L, Schaeffer HJ (December 1977). "Selectivity of action of an antiherpetic agent, 9-(2-hydroxyethoxymethyl) guanine". Proceedings of the National Academy of Sciences of the United States of America. 74 (12): 5716–5720. Bibcode:1977PNAS...74.5716E. doi:10.1073/pnas.74.12.5716. PMC 431864. PMID 202961.
- ^ US 4146715, Schaeffer HJ, "2-Amido-9-(2-acyloxyethoxymethyl)hypoxanthines", issued 27 March 1979, assigned to Burrough Wellcome Co.
- ^ Vince R (2008). "A brief history of the development of Ziagen". Chemtracts. 21: 127–134.
- ^ "The Nobel Prize - Gertrude B. Elion".
- ^ "Valacyclovir Hydrochloride Monograph for Professionals". Drugs.com. American Society of Health-System Pharmacists. Retrieved 17 March 2019.
- ^ "Drug Approval Package: Acyclovir and Hydrocortisone NDA #022436". U.S. Food and Drug Administration (FDA). 13 December 2019. Archived from the original on 13 December 2019. Retrieved 13 December 2019.
This article incorporates text from this source, which is in the public domain.
- ^ "Xerese- acyclovir and hydrocortisone cream". DailyMed. 12 December 2019. Archived from the original on 13 December 2019. Retrieved 12 December 2019.
- ^ Papich M (2016). Saunders Handbook of Veterinary Drugs (4th ed.). Elsevier. ISBN 978-0-323-24485-5.
Further reading
- Hazra S, Konrad M, Lavie A (August 2010). "The sugar ring of the nucleoside is required for productive substrate positioning in the active site of human deoxycytidine kinase (dCK): implications for the development of dCK-activated acyclic guanine analogues". Journal of Medicinal Chemistry. 53 (15): 5792–5800. doi:10.1021/jm1005379. PMC 2936711. PMID 20684612.
- Harvey SC (1990). "Drug absorption, action and disposition". In Remington JP, Gennaro AR (eds.). Remington's Pharmaceutical Sciences (18th ed.). Easton, Pa.: Mack Pub. Co. pp. 697–702. ISBN 978-0-912734-04-0.
- Huovinen P, Valtonen V (1994). Neuvonen PJ (ed.). Kliininen Farmakologia (in Finnish). Helsinki: Kandidaattikustannus Oy. ISBN 951-8951-09-8.
- Périgaud C, Gosselin G, Imbach JL (1992). "Nucleoside analogues as chemotherapeutic agents: a review". Nucleosides and Nucleotides. 11 (2–4): 903–945. doi:10.1080/07328319208021748.
- Rang HP, Dale MM, Ritter JM (2003). Pharmacology (5th ed.). Pearson Professional Ltd. ISBN 0-443-07145-4.


